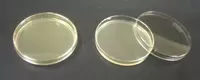
от {0} сум Фенилаланин агар

Фенилаланин агар
В наличии Код: P-0654515TM 260 Фенилаланин агар
Для дифференциации Proteus и Provedencia от остальных видов семейства Энтеробактерий основываясь на способности образовывать фенилпируват из фенилаланина.
Страна: Индия
Производитель: Titan Biotech Ltd
* Обезвоженный порошок, гигроскопичен, хранить в сухом месте, в плотно закрытой таре при температуре ниже 25 ° C и защищать от прямых солнечных лучей.
Инструкции по использованию
Растворить 26 г продукта в 1000 мл дистиллированной воды. Осторожно нагреть до кипения при легком перемешивании и растворить среду полностью. Стерилизовать автоклавированием при 1,1 атм (121 ° С) в течение 15 минут. Не перегревать. Охладить до температуры 45 – 50 ° С и разлить в стерильные чашки Петри
Внешний вид: Слегка мутный гель желто-коричневого цвета.
рН (при 25 ° С): 7,3 ± 0,2
Принцип действия:
Фенилаланин агар используется для дифференциации Proteus и Providencia от других членов
Enterobacteriaceae, на основе их способности образовывать фенильный пировиноградной кислоты из фенилаланина, описанного по Юинга, Дэвис и Reavis. DL-фенилаланин служит источником аминокислот. Дрожжевой экстракт обеспечивает витамины, особенно витамин B-комплекс и другие питательные вещества для роста. Хлорид натрия обеспечивает осмотическое равновесие. Динатрий фосфата является буфером, а Агар служит застывающим агентом. Добавление 4 до 5 капель 10% -ного хлорида железа, который производит фенилпировиноградную кислоту в инкубированной трубке. Он вступает в реакцию с побочным продуктом, чтобы произвести свет темно-зеленый цвет. Proteus SPP, Morganella SPP и Providencia SPP. дезаминируют фенилаланин, в то время как другие кишечные бактерии не обладают специфического фермента и, Таким образом, дают отрицательную реакцию. Некоторые бактерии производят ферменты, которые могут метаболизировать аминокислоты. Эта группа бактерий производят фермент фенилаланин деаминазу который удалит группу амина (NH 2) и выпустить его в качестве свободного аммиака (NH3). До того, как аминокислоты, могут быть использованы клеткой в качестве источника энергии, аминогруппа должна быть удалена, этот процесс называется дезаминирование. Непосредственным появление интенсивный зеленый цвет (1 – 5 минут) указывает на присутствие фенилпировиноградной кислоты.
Интерпретация результатов
Культурные характеристики, наблюдались после инокуляции (103 КОЕ / мл), при инкубации при 35ᵒ ± 2 С в течение 18-24 часов.
К данному товару отзывов пока нет.

Информация о данном продавце была проверена через систему Soliq.uz и подтверждена как достоверная
Подробнееbu yerda xarid qilib bolmaydi korupsiya faqat ozlarini odamlari blan ishlashadi bu magazin emas ekan
Добавить отзыв